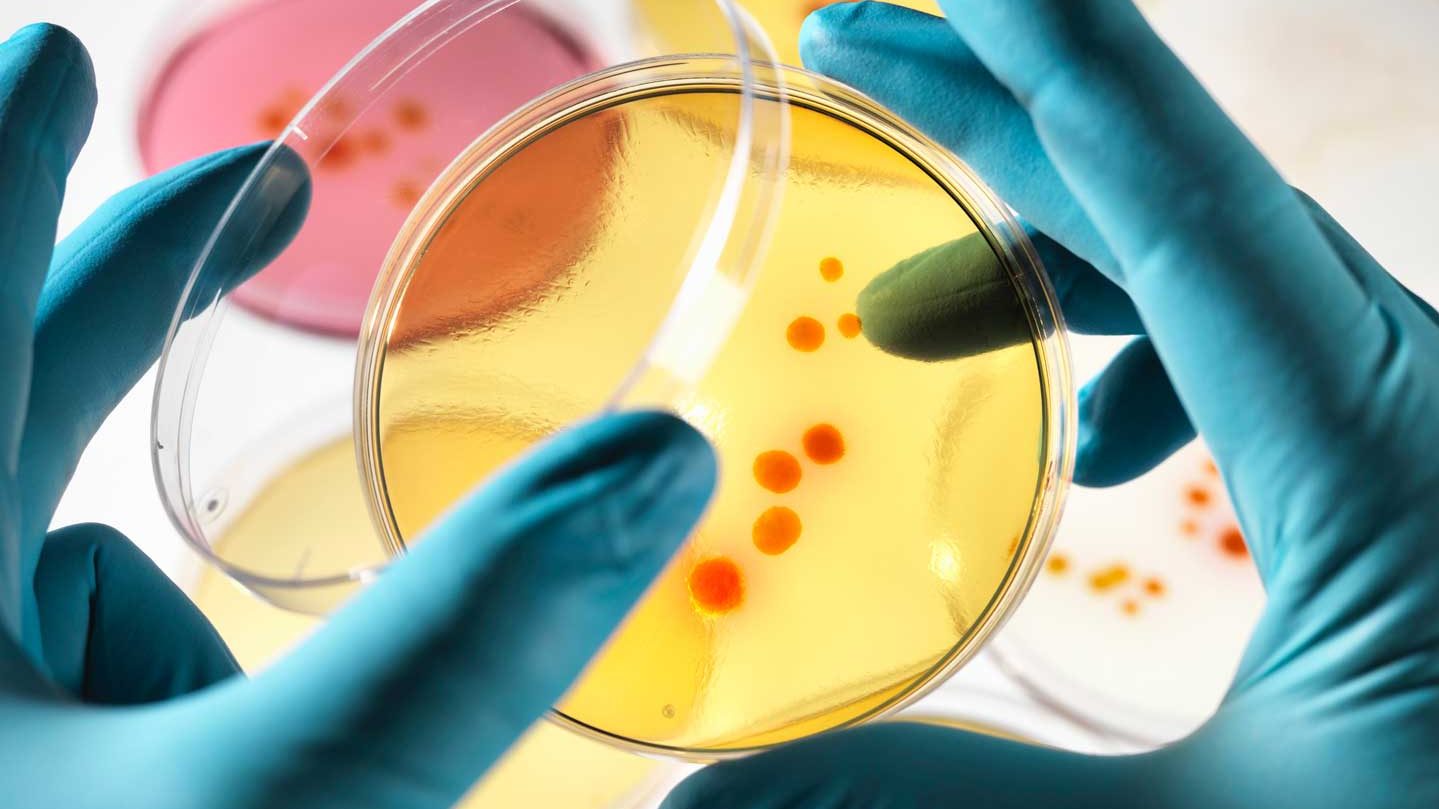

A cure for cancer could save millions of lives … or destroy them.
John Sotos, chief medical officer at Intel, is concerned that the same technology that could be used to eradicate disease might also be used to create a bioweapon capable of accurately targeting certain people and rewriting their DNA.
At the DEF CON hacking conference in Las Vegas, the Intel executive warned that Joe Biden’s “cancer moonshot” initiative, which aims to produce cancer-treating vaccinations, could open Pandora’s Box. Although the technology doesn’t exist yet, he believes it’s inevitable.
According to The Guardian, the main reason why bioweapons aren’t a bigger threat today is that scientists haven’t figured out a way to hack the human genome with the accuracy that’s needed. Without that, there’s no guarantee a bioweapon would stop spreading and wouldn’t be able to be contained to a specific individual or country.
Soto warns that Biden’s “moonshot initiative” would provide that specificity that allows bioweapons to target individuals using elements in their DNA that identify ancestry, gender, or family. The potential attacks he described that weren’t exclusive to genocide, The Guardian reports. “There’s some stuff worse than dying,” Sotos said. “And I call that hell.”
This article appeared in an InsideHook newsletter. Sign up for free to get more on travel, wellness, style, drinking, and culture..